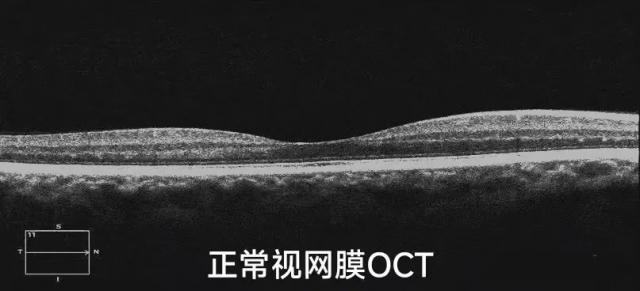

引語:ICL術前那么多不同的檢查項目,它到底檢查了眼睛的哪些結構,又有什么作用呢?小篇來為大家詳細解答。
角膜地形圖檢查

儀器:Pentacam(眼前節分析儀)
功能:檢查角膜形態、前房容積的大小;排查圓錐角膜,前房深度是否符合做ICL手術指標。
視覺質量分析檢查

儀器:ITrace(視覺質量分析儀)
功能:用于檢查眼像差,評估術前術后的視覺質量。
結果示例
術前視覺質量

術后視覺質量

視網膜檢查

儀器:OCT(光學相干斷層學檢查)
功能:排查高度近視引起的眼底病變、視網膜脫離、青光眼視神經損害等眼底病變。
結果示例

眼部B超檢查

儀器:B型超聲診斷儀
功能:排查眼內、眶內病變,如視網膜脫離、眼內及眼眶腫瘤等。
結果示例



眼底照相檢查

儀器:Optos(超廣角眼底照相)
功能:用于眼底視網膜檢查,排查視網膜變性、裂孔,視網膜脫離等病變。
結果示例


UBM檢查

儀器:UBM(超聲生物顯微鏡)
功能:主要檢查前房深度、房角、睫狀溝距離等,目的排查睫狀溝占位性病變和匹配合適ICL晶體尺寸。
結果示例


總結:以上介紹的部分專項檢查都是為了全面了解我們的眼部情況,排查手術禁忌癥,為主刀醫生提供準確的ICL手術所需參數。完成一遍術前檢查就相當于給眼睛做一次全面健康體檢,我們工作人員都會拿出專業的技術為大家眼睛健康保駕護航,總共花的時間較長,請大家耐心等候哦。